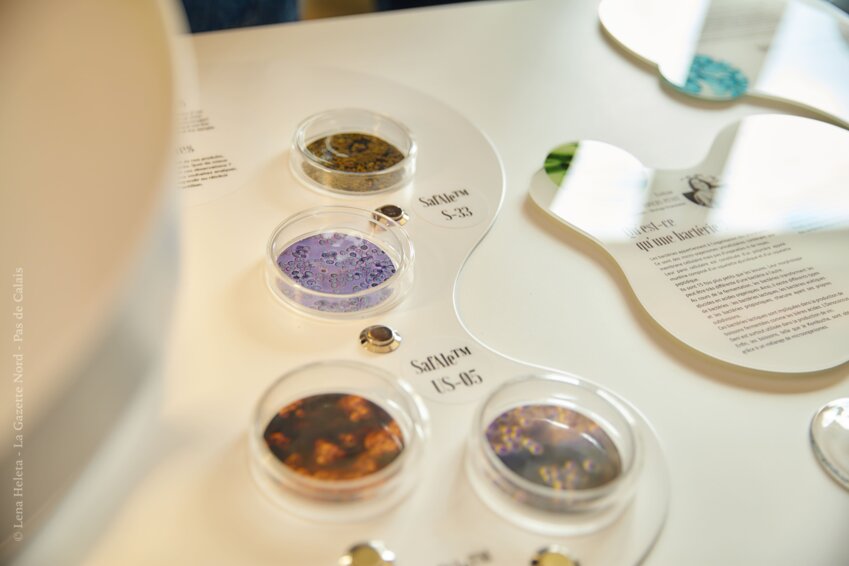

Grâce à ce rachat, Yeap permettra à
Lesaffre d'investir le marché des protéines alternatives
fonctionnelles, un nouvel ingrédient innovant. Yeap et Lesaffre
envisagent de faire de la levure une source évidente de protéines
sur le marché croissant des protéines d'origine végétale, en
produisant la protéine recyclée polyvalente et avec l'un des
impacts environnementaux les plus faibles du marché. Fondée en 2020, Yeap est l'une des premières entreprises au monde à produire des protéines à partir de levures en intégrant un modèle d'économie circulaire.
Cet investissement servira l'une des
activités de Lesaffre dédiée au goût et au plaisir alimentaire,
Biospringer by Lesaffre, acteur majeur et producteur mondial
d'extraits de levure d'origine naturelle et d'autres dérivés de
micro-organismes pour l'industrie alimentaire.